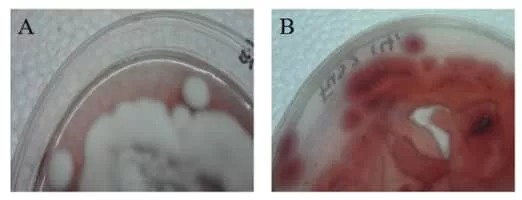

Lecanicillium
| Use attributes for filter ! | |
| Scientific name | Lecanicillium |
|---|---|
| Rank | Genus |
| Higher classification | Cordycipitaceae |
| Date of Reg. | |
| Date of Upd. | |
| ID | 1586281 |
About Lecanicillium
Lecanicillium is a genus of fungi in the order Hypocreales and is described as anamorphic Cordycipitaceae; 21 species are currently described. Some of these entomopathogenic fungus species were previously widely known as Verticillium lecanii Viegas.